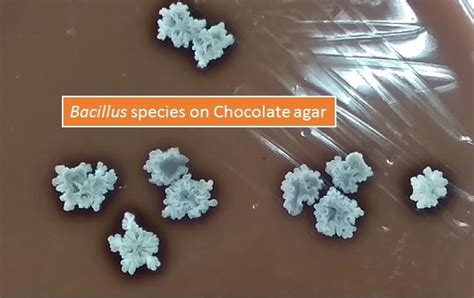
bacillus species introduction classification   bacillus anthracis

Jika kamu sedang mencari Bacillus Species, maka anda berada di halaman yang tepat. Kami menyediakan aneka Bacillus Species yang bisa anda pesan online. Silakan hubungi kami via +6282245078486, jangan lupa sertakan juka gambar yang diinginkan.
Kami mengirim paket Bacillus Species melalui berbagai ekspedisi, misalnya JNE, JNT, POS, dll. Kami juga menerima pembayaran via BCA/Mandiri/dll. Pengiriman biasanya tidak sampai seminggu sudah sampai dan kami sertakan pula nomor resi yang bisa digunakan untuk tracking barang secara online.

Tidak hanya Bacillus Species, anda juga bisa melihat gambar lain seperti
Gram Stain,
Aerobic or Anaerobic,
Antibacterial Activity,
Identification Flow Chart,
Gram-positive Rods,
Blood Agar,
Catalase Positive,
Urine Test,
Lecithinase Reaction,
Blood Culture,
Agar Plate,
Tattoo Ink,
FlowChart,
Froming Spores,
Growth Agar,
Orange Ring Forming,
Functions,
Small GPR,
Biochemical Chart,
Elemental Composition,
Identification Colony,
Important for Pectinase,
and That Is Mucoid Anaerobically.
Berbagai Contoh Bacillus Species
Berikut kami sertakan berbagai contoh gambar untuk Bacillus Species, silakan save gambar di bawah dengan klik tombol pesan, anda akan kami arahkan pemesanan via WA ke +6282245078486.
 1599×1102
1599×1102
bacillus definition features types britannica
Order Sekarang
 2560×1493
2560×1493
bacillus distinguishing species strains part ii microbial
Order Sekarang
 800×576
800×576
rod shaped bacillus bacteria stock image science photo
Order Sekarang
 3484×1960
3484×1960
rod shaped endospore forming bacillus bacteria stock photo
Order Sekarang
 500×239
500×239
rod bacillus bacteria prokaryotes flashcards quizlet
Order Sekarang
 1600×1061
1600×1061
bacillus gram positive spore forming bacterium form
Order Sekarang
 598×598
598×598
bacillus bacteria bacillus bacteria rod shaped bacteria
Order Sekarang
 1024×576
1024×576
bacillus subtilis morphology gram stain molecular microbiology
Order Sekarang
 1600×1071
1600×1071
bacillus gram positive spore forming bacterium form rods rods
Order Sekarang
 258×302
258×302
bacillus spp gram positive rods scientific diagram
Order Sekarang
 1500×1536
1500×1536
bacillus cereus gram positive rod shape gram stainig
Order Sekarang
 500×244
500×244
gram positive endospore forming bacteria bacillus clostridium
Order Sekarang
 1500×1255
1500×1255
emergence rodshaped bacillus thuringiensis bacteria vegetative stock
Order Sekarang
 1500×1593
1500×1593
endospore bacillus microscope bacillus stock photo
Order Sekarang
 1300×1064
1300×1064
rod shaped bacillus bacteria gloria moreno blog
Order Sekarang
 1042×1390
1042×1390
scanning electron micrograph sem bacillus subtilis gram positive
Order Sekarang
 1500×1101
1500×1101
bacillus genus gram positive rod shaped bacteria member stock photo
Order Sekarang
 1000×667
1000×667
bacillus genus gram positive rod shaped bacteria member
Order Sekarang
 720×540
720×540
gram positive endosporeforming bacilli genus bacillus dr
Order Sekarang
 1600×1167
1600×1167
bacillus genus gram positive rod shaped bacteria member phylum
Order Sekarang
 700×416
700×416
solved organism bacillus demo gram positive rods cheggcom
Order Sekarang
1080×1612
1080×1612
bacillus subtilis gram positive rod shaped bacterium forms
Order Sekarang
 1024×576
1024×576
bacillus introduction morphology pathogenicity lab diagnosis
Order Sekarang
 1024×682
1024×682
bacillus genus grampositive rodshaped bacteria member
Order Sekarang
Temukan solusi terbaik untuk kenyamanan ruang Anda dengan Bacillus Species! Produk peredam suara dan panas ini menawarkan performa maksimal dengan harga yang terjangkau. Dapatkan kualitas unggul tanpa menguras kantong, dan nikmati suasana tenang serta sejuk di setiap sudut rumah atau kantor Anda. Pilih Bacillus Species – pilihan cerdas untuk investasi jangka panjang!










